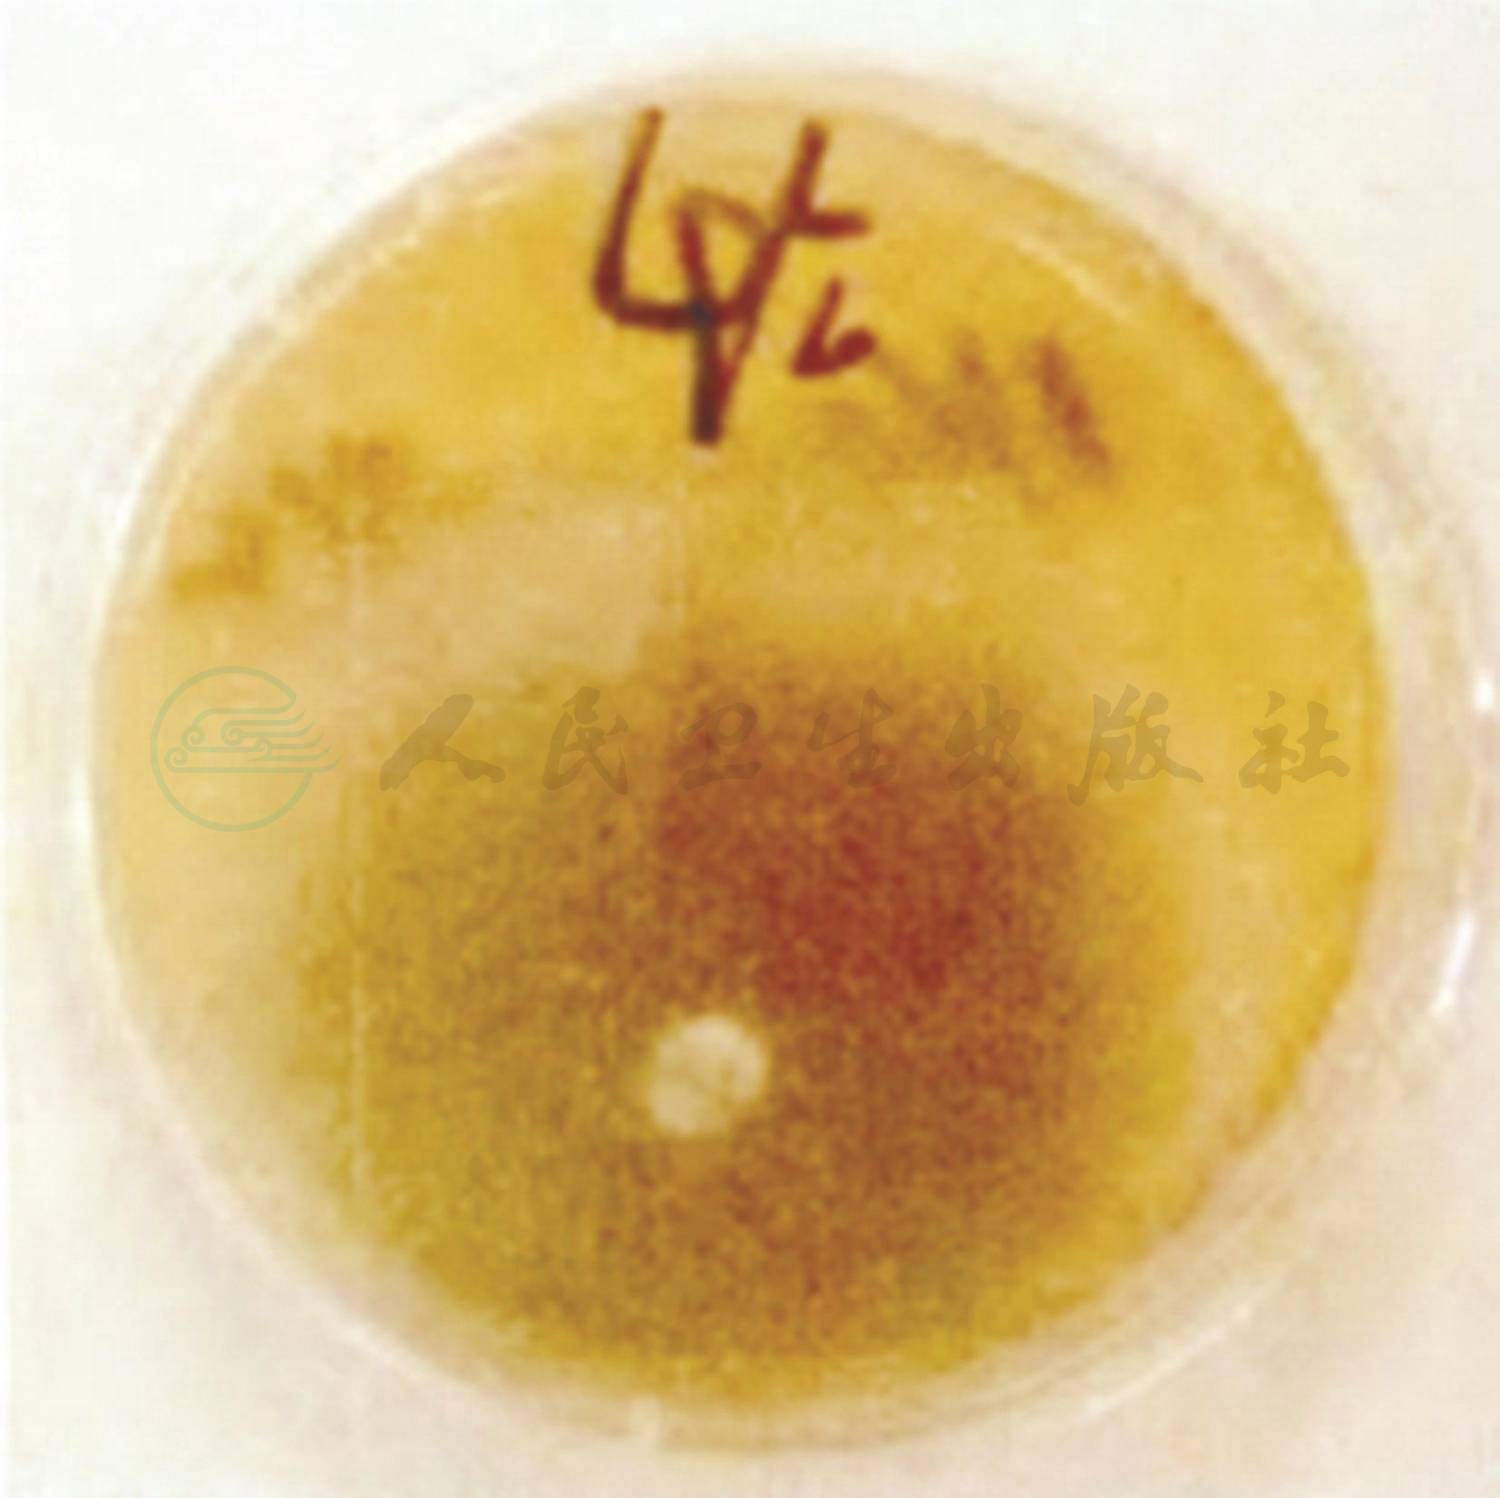

患儿,女,1岁5个月。
主诉:反复咳喘伴间断发热2个月。
现病史:患儿2个月前因咳嗽、喘息、气促就诊于当地医院,X线胸片示支气管肺炎,遂于当地医院住院治疗。期间患儿出现发热,并因喘息加重、呼吸困难及心力衰竭转入ICU机械辅助通气11天撤机。期间出现气胸 1次,行胸腔闭式引流术后缓解。患儿自发病来连续静滴抗生素、吸入支气管扩张剂,间断应用静脉糖皮质激素平喘(用药天数不详),发热、咳嗽及喘息症状未见好转,3次查肺部CT均提示双肺透过度不均匀,双肺炎症,右肺部分实变。为求进一步诊治来笔者科室住院治疗。
既往史:患儿既往体健,无喘息史,无家族喘息性疾病史。
过敏及接触史:否认食物及药物过敏史。否认肝炎、结核等传染病接触史。
个人及家族史:生长发育同同龄儿,按时进行预防接种,否认肝炎、结核等家族史。
入院查体及相关检查:体温37.80℃;脉搏170次/min;呼吸46次/min;血压102/70mmHg;体重12kg。神志清楚,精神状态差,口周发绀,鼻翼扇动及三凹征阳性,双肺听诊呼吸音粗,可闻及广泛的喘鸣音及痰鸣音,心音有力、律齐,未闻及病理性杂音。腹软,不胀,肝肋下3cm,Ⅱ度硬,脾肋下未触及。四肢温,CRT 2秒,肌力及肌张力正常,神经系统查体未见阳性体征。
辅助检查:肺CT(当地医院,入院前2周)(图1):双肺透过度不均匀,双肺炎症,右肺部分实变。肺CT(笔者医院门诊)(图2A,图2B):双肺透过度不均匀,呈马赛克征改变,多叶段炎症,右肺部分实变,双肺散在肺气囊形成。


图1 入院前2周,当地医院肺CT

图2A 入院前笔者医院门诊肺CT


图2B 入院前笔者医院门诊肺CT
入院后完善各项检查:血常规、CRP等感染指标均正常;肺炎支原体抗体-IgM、IgG抗体均阴性;肺炎衣原体抗体阴性;结核抗体(TBAb)、常见呼吸道、肠道病毒及肝炎病毒检测均阴性,血细菌培养未见细菌生长,结核菌素试验阴性,G试验、GM试验阴性;免疫球蛋白及T淋巴细胞亚群无特殊异常。入院后予抗感染、布地奈德联合复方异丙托溴铵泵吸平喘治疗,但患儿喘息缓解不明显,结合病例特点及肺CT呈马赛克征改变,考虑为闭塞性细支气管炎,加用甲泼尼龙片[2mg/(kg·d),间隔 12 小时 1 次]、小剂量红霉素[5mg/(kg·d),每天2次]、乙酰半胱氨酸(600mg/次,每天1次)口服。期间患儿仍出现2次喘息加重及呼吸困难,均将口服甲泼尼龙片更换为静脉滴注甲泼尼龙琥珀酸钠[2mg/(kg·d)]、氨茶碱,患儿喘息略缓解。再次复查肺 CT(图3)示双肺多叶、段炎症部分吸收,右肺仍见部分实变改变较前未见明显变化,建议家属进一步完善支气管镜,行支气管肺泡灌洗术,以帮助明确病原,指导治疗,但家属拒绝。因患儿体温逐渐平稳,咳喘缓解,住院26天出院。出院医嘱:①口服甲泼尼龙片12mg,每天2次;②小剂量红霉素30mg/次,每天2次[5mg/(kg·d)];③乙酰半胱氨酸600mg/次,每天1次;④钙尔奇D 300mg/次,每天2次口服;⑤泵吸布地奈德0.25mg+生理盐水1ml/次,每天2次;⑥2周后门诊复查。
出院后13天因咳喘加重再次入院,双肺听诊可闻及中等量的湿啰音及喘鸣音,复查肺CT较前无明显改变。家属同意完善支气管镜检查,行第1次支气管肺泡灌洗术,镜下(图4)见支气管及右主支气管的黏膜有黄白色干酪样物质附壁,刷检并取肺泡灌洗液检查,未查出病原学阳性证据。3天后第2次行支气管肺泡灌洗术和活检,病理检查结果(图5)示见较多霉菌菌丝,细菌涂片见大量的真菌菌丝,疑似曲霉菌,细菌培养结果(图6)为烟曲霉菌生长。确诊为闭塞性细支气管炎合并肺曲霉菌病,遂予加用静脉滴注伏立康唑治疗[首日6mg/(kg·次),间隔12小时1次;第2天始4mg/kg,间隔12小时1次]。静滴伏立康唑1周后喘息症状较轻明显缓解,安静状态下无喘息及呼吸困难,活动后仍有喘息,改为伏立康唑片口服治疗5天(100mg/次,间隔12小时1次),喘息无加重,肺部听诊可闻及散在痰鸣音及少许喘鸣音,住院17天出院。出院医嘱:①口服伏立康唑片(100mg/次,间隔12小时1次);②口服甲泼尼龙片12mg,每天2次;③小剂量红霉素100mg/次,每天2次[5mg/(kg·d)];④乙酰半胱氨酸 600mg/次,每天 1 次口服;⑤钙尔奇 D 300mg/次,每天2次口服;⑥泵吸布地奈德0.25mg+生理盐水1ml/次,每天2次;⑦2周后门诊复查。

图3 入院后复查肺CT

图4 纤维支气管镜检查镜下改变

图5 支气管镜肺泡灌洗液及黏膜活检的病理结果
图6 肺泡灌洗液细菌培养结果:烟曲霉菌生长
闭塞性细支气管炎合并肺曲霉菌病。
诊断依据:①临床表现:咳嗽、喘息、反复发热近2个月,经抗生素和支气管舒张剂治疗效果不理想。②肺HRCT提示:双肺透过度不均匀,呈马赛克征改变,多叶段炎症,右肺部分实变,双肺散在肺气囊形成。③镜下见支气管及右主支气管的黏膜有黄白色干酪样物质附壁,活检病理结果示:见较多霉菌菌丝;肺泡灌洗液细菌涂片见大量的真菌菌丝,肺泡灌洗液细菌培养为烟曲霉生长。
1.闭塞性细支气管炎
闭塞性细支气管炎(bronchiolitis obliterans,BO)是一种由严重小气道炎症损伤引起的少见的慢性气道阻塞性肺疾病。BO的发生与多种原因有关,任何原因导致细支气管黏膜及黏膜下结构炎症与损伤,且修复不当均可导致BO。BO常见病因有呼吸道感染、心肺或骨髓移植、吸入有毒物质、胃食管反流、结缔组织病及药物性等。儿童BO 多由急性下呼吸道感染引起,尤其是病毒感染,被认为是急性呼吸道病毒感染的后遗症。该病目前缺乏确切有效的治疗方案,预后不确定,病程长,病情易反复或加重。
目前认为儿童BO的发生是感染导致细支气管上皮细胞损伤,在上皮细胞修复过程中发生异常的炎症反应和纤维化。主要的病理改变为细支气管黏膜、黏膜下或管壁外周炎性细胞浸润和纤维化致管腔狭窄,管腔内无肉芽组织形成,邻近肺实质很少受累。轻者仅有炎性细胞浸润、细支气管上皮细胞坏死,随病变进展,管壁胶原组织产生,逐渐发生向心性纤维化和瘢痕收缩,造成管腔缩窄与扭曲,严重时管腔完全闭塞。细支气管狭窄、闭塞后气体吸收使肺萎陷,分泌物滞留继发感染而导致大气道的支气管扩张。病变区域长期慢性缺氧可使该区域肺血管容积或数量减少。
BO的临床症状和体征轻重不一,可呈急性或亚急性起病,从轻微的哮喘样症状到快速进行性恶化及死亡。主要表现为反复咳嗽、喘息,活动后加剧,运动耐受性差,重者呈慢性持续症状。轻症患儿可无症状,呼吸道感染时出现咳嗽、气喘。病程数月或数年,支气管舒张剂不能明显改善上述症状,呼吸增快、肺部湿啰音及哮鸣音是最常见体征,可有吸气性三凹征,严重者出现胸廓畸形、杵状指、肺动脉高压。患儿易发生反复呼吸道感染,感染可加重BO病情,重者可在 1~2 年内死于呼吸衰竭。
HRCT在诊断小呼吸道病变中敏感性的提高,使早期诊断BO 成为可能。BO 患儿HRCT 表现以马赛克灌注征、支气管壁增厚、支气管扩张及呼气相气体潴留为特征。马赛克灌注征表现为肺野内斑片样分布的含气不均匀征象,呈高通气与低通气区混合,称镶嵌形式。其中透亮度增高的区域是BO的病变区域,其内血管纹理减少;而周围透亮度减低的区域是对病变区域的代偿。这些特征特异性较高,但其诊断敏感性略显不足。
肺组织活检是诊断PIBO的金标准,但肺活检不一定能取到病变组织,且病理改变多为轻度炎症或纤维化,易致漏诊,临床诊断为BO的患儿中约1/3肺活检显示正常或无法确诊。因此肺活检并不总是具有诊断价值,但对于临床及HRCT表现不典型或病情迅速进展者,仍应早行肺活检。
BO 的诊断要点:①急性下呼吸道感染或明显诱因后出现持续喘息或咳嗽、气促、呼吸困难,症状持续达6周以上,支气管扩张剂治疗无效;②临床表现与X线胸片表现不符,临床症状重,X线胸片多表现为过度通气,也可表现为单侧透明肺;③肺HRCT显示马赛克灌注征、支气管壁增厚、支气管扩张、肺不张等;④肺功能显示阻塞性通气功能障碍,支气管扩张试验阴性;⑤排除其他引起喘息的疾病,如支气管哮喘、原发性纤毛运动障碍、囊性纤维性变、异物吸入、先天性支气管发育异常、肺发育异常、肺结核、艾滋病和其他免疫功能缺陷等。
目前BO治疗困难,多采用糖皮质激素与支气管扩张剂合用,辅以大环内酯类药物口服治疗。长期使用糖皮质激素虽不能逆转已形成的气道阻塞,但可减轻气道高反应性和继发于病毒感染或过敏的支气管狭窄。糖皮质激素使用途径、剂量、疗程无统一标准。有学者推荐口服甲泼尼龙1~2mg/(kg·d),足量用1~3个月后依病情逐渐减量,总疗程1年,病重者治疗初期可给予甲泼尼龙1~2mg/(kg·d)静脉滴注,3~5天后改为口服甲泼尼龙治疗。在全身糖皮质激素治疗同期可辅以糖皮质激素吸入治疗。也有学者推荐静脉甲泼尼龙冲击疗法,30mg/(kg·d)(最大不超过1g),连用 3天,每月重复 1次,共 3~6个月,用于严重BO患儿,可减少长期全身用药的不良反应。
BO患儿喘息加重时使用短效β2受体激动剂可部分缓解阻塞症状。长效β2受体激动剂不单独使用,常作为减少吸入性糖皮质激素用量的联合用药。BO患儿易发生反复呼吸道感染,需根据病原选择相应抗生素。大环内酯类有基于抗菌活性之外的抗炎活性、免疫调节和改善肺功能作用。因此,大部分BO患儿同时口服大环内酯类药物治疗。
充分营养支持,预防呼吸道感染,避免被动吸烟对BO患儿亦很重要。对局部支气管扩张、慢性肺叶不张保守治疗不理想者可考虑外科手术治疗。持续严重的气流阻塞、肺功能逐渐恶化者可行肺移植。
BO的预后不确定,与BO的病因及初期肺损伤严重程度有关。病情严重者常死于进行性呼吸衰竭,多数病例遗留肺过度充气、肺膨胀不全和支气管扩张等后遗症。症状反复或持续存在且伴反复呼吸道感染者,肺功能逐渐恶化。
2.肺曲霉菌病
近年来,在儿童中随着广谱抗生素的广泛应用、各种导管的留置及呼吸机的普及等,侵袭性真菌感染受到了人们越来越多的关注。但由于患儿临床上缺乏特异性表现,易被原发疾病的症状、体征所掩盖,故漏诊率、病死率均较高。其中侵袭性曲霉菌感染尽管发生率低于白色念珠菌,但近年来病死率持续升高,位居真菌感染中第一位。目前被认识的曲霉菌有175余种,据报道人类疾病密切相关的有19种,最常见的致病曲霉菌包括烟曲霉菌、黄曲霉菌、黑曲霉菌、土曲霉菌、构巢曲霉菌,人类曲菌病95%以上由烟曲霉菌引起。
儿童真菌感染与多种因素有关,宿主和环境危险因素:①基础疾病:早产儿、低出生体重儿、先天发育异常、慢性疾病和重度营养不良等。②原发性免疫缺陷病:各类原发性免疫缺陷病,尤其是联合免疫缺陷病、细胞免疫缺陷病和慢性肉芽肿病(CGD)等。③继发性免疫功能低下:抗肿瘤药物导致外周血中性粒细胞减少;长期应用广谱抗菌药物、糖皮质激素以及其他免疫抑制剂;骨髓移植和器官移植后以及HIV感染和其他严重病毒感染等。④侵入性操作:包括血管内留置导管、留置导尿管、气管插管或气管切开、机械通气、腹膜透析、血液净化和胃肠外营养等。⑤环境危险因素:免疫功能基本正常的儿童,由于吸入大量真菌孢子,如空调污染、密切接触鸽类以及接触有真菌存在的环境,超过机体抵抗力而发病,多见于肺隐球菌病,其次是侵袭性肺曲霉病。
慢性肺部疾病合并侵袭性肺曲霉菌病的发病机制主要是肺结构性改变,黏液纤毛功能障碍,气道屏障作用减弱,以及肺表面活性蛋白A、D缺乏或异常。吸入空气中的曲霉菌后容易在气道定植,当免疫功能低下时导致肺部曲霉菌感染。相关研究表明,中性粒细胞可阻止曲霉菌菌丝的形成,而单核细胞则主要影响分生孢子,吞噬细胞和中性粒细胞功能的降低可增加曲霉菌感染的风险。糖皮质激素不仅有助于真菌的快速生长,而且还可改变吞噬细胞、中性粒细胞的吞噬功能,干扰杀死菌丝和孢子的过程。
侵袭性肺曲霉菌病的临床表现往往呈现非特异性,主要表现为咳嗽、发热、咳痰、咯血、呼吸困难、胸痛等呼吸道症状,查体可以有肺部湿啰音或干啰音,可出现胸腔积液。支气管镜下的表现可以正常,部分患者可见支气管腔内多发结节,结节样或息肉样新生物,气管外压性狭窄或气管内大量白色干酪样物质。有文献报道,对可疑侵袭性肺曲霉菌病的患儿应用纤维支气管镜获取支气管肺灌洗液进行病原学检测是安全和有用的方法,敏感性和特异性分别为50%和97%。
影像学表现多样,但也缺乏特异性,侵袭性肺曲霉病的典型影像学征象:早期出现胸膜下密度增高的结节实变影和/或楔形实变影、团块状阴影,病灶周围可有晕轮征,数天后肺实变区液化、坏死,出现空腔阴影或新月形空气征。慢性气道疾病合并侵袭性肺曲霉菌病时的胸部影像学检查无特异性,但若经抗生素治疗后肺实变阴影不吸收,或者出现新的病灶,以及肺部出现单发或多发空洞阴影,在排除细菌、结核感染和肿瘤后需考虑合并侵袭性肺曲霉菌病的可能。
对于肺部真菌感染,有确诊意义的微生物学证据包括:①肺组织真菌培养阳性;②胸腔积液真菌培养阳性;③血液真菌培养阳性;④合格痰液或支气管肺泡灌洗液发现肺孢子菌包囊、滋养体或囊内小体;⑤胸腔积液和血液直接镜检发现新生隐球菌。组织病理学证据是:肺组织标本进行组织病理学检查发现真菌感染的病理改变以及菌丝或孢子等真菌成分。
根据中华医学会制定的《儿童侵袭性肺部真菌感染诊治指南》,肺部曲霉菌病的诊断标准分为确诊、临床诊断及拟诊三个层次,其中确诊是指:有宿主因素+临床证据+肺组织病理学和/或有确诊意义的微生物学证据。临床诊断是指:有宿主因素+临床证据+有临床诊断意义的微生物学证据。拟诊是指:宿主因素+临床证据。
肺曲霉病的治疗可选择伏立康唑、伊曲康唑、卡泊芬净、两性霉素B,病情重者可联合两种抗真菌药物治疗。氟康唑对肺曲霉感染无效。可参考病情的轻重、原发病、免疫功能状态以及药物的安全性和价格等选择药物。两性霉素B是治疗侵袭性肺曲霉病的传统药物。目前认为病情较重者,可首选伏立康唑。卡泊芬净适用于患者不能耐受其他药物或其他药物无效时的治疗。由于伏立康唑对侵袭性肺曲霉菌病有较好的疗效,且不良反应较小,目前已成为治疗侵袭性曲霉菌感染的一线药物。对于儿科患者,目前推荐的伏立康唑剂量为7mg/(kg·次),每 12小时1 次,静脉滴注;或第 1天6mg/(kg·次),每12小时 1次,随后4mg/(kg·次),每12小时1次,静脉滴注。口服剂量:体重<40kg,100mg/次,每12小时1次;体重≥40kg,200mg/次,每12小时1次。治疗的时间长短,因病情而异,给药时间不宜过短,一般6~12周,甚至更长,一般治疗至临床症状消失,影像学示病变基本吸收。总之,要对病情进行综合分析,要追踪观察,治疗应个体化。
(王天玥 尚云晓)



